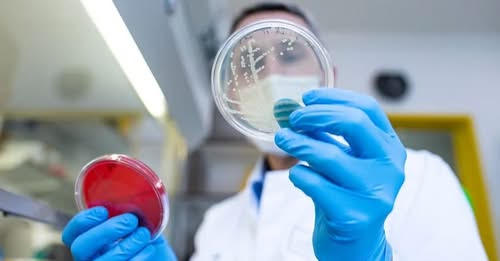

A Mandiner cikkére hivatkozva reagált a Tisza-adóra.
 A miniszterelnök a Mandiner cikkére hivatkozva – azt a hozzászólások között megosztva – reagált arra a hírre, hogy Magyar Péter és a Tisza Párt új adó(kat) vetnének ki, ha kormányra kerülnének.
A miniszterelnök a Mandiner cikkére hivatkozva – azt a hozzászólások között megosztva – reagált arra a hírre, hogy Magyar Péter és a Tisza Párt új adó(kat) vetnének ki, ha kormányra kerülnének.

Olaszország és Csehország is hazánkhoz hasonló álláspontot képvisel: https://mandiner.hu/kulfold/2025/08/ketteszakadt-europa-egyertelmuve-valt-melyik-tabort-erositi-magyarorszag

A kislány csak három év elteltével mert…

Már felvétel is bizonyítja, hogy valóban progresszív adórendszert vezetne be a Tisza Párt. Magyar Péter emberei egy vidéki fórumon mondták el, hogy egyelőre csak maguk közt beszéljenek az adóemelésről…
Csak ez számít nekik.

Paláver, a HírTV és a HírFM közös műsora
Paláver, a HírTV és a HírFM közös műsora

Ráadásul egyr súlyosabb a helyzet.